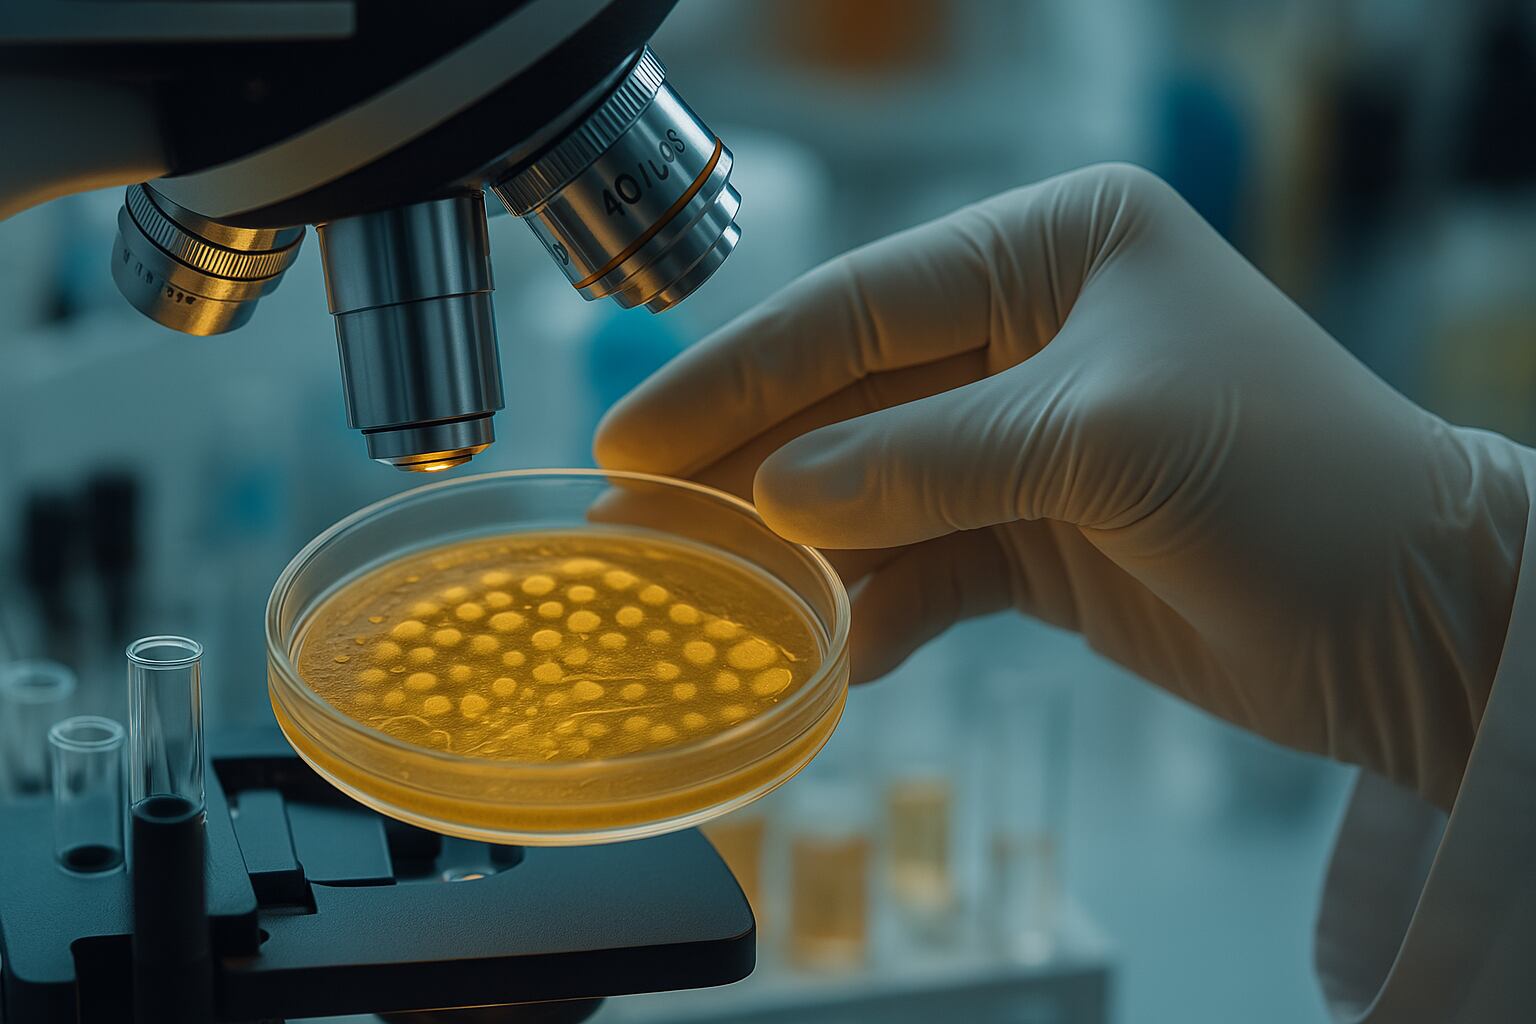
En 2025 ya se reportaron 19 muertes por influenza en personas internadas según el Boletín Epidemiológico Nacional del Ministerio de Salud (Imagen Ilustrativa Infobae)

Un estudio realizado en el Hospital Ramos Mejía reveló que más del 70% de los adultos internados por neumonía causada por el virus de la influenza no estaba vacunada, a pesar de que todos los pacientes tenían indicación médica de recibir la inmunización.
El dato pone en evidencia no solo una oportunidad desaprovechada desde el punto de vista sanitario, sino también el costo que representa para el sistema de salud una enfermedad que puede prevenirse.
La investigación se enfocó en los casos atendidos entre 2022 y abril de 2023 en una institución pública de referencia en la ciudad de Buenos Aires. Todos los pacientes incluidos en la muestra fueron diagnosticados con neumonía vinculada a la influenza. Solo el 28,5 % había recibido la vacuna antigripal en la temporada previa, pese a que el 100 % presentaba criterios para su aplicación.

La neumonía figura entre las complicaciones más severas del virus de la influenza. Cuando la infección se instala en los pulmones, el cuadro clínico puede agravarse, especialmente en grupos vulnerables. Personas mayores, adultos con enfermedades crónicas, inmunosuprimidos y quienes presentan afecciones respiratorias de base, son los más expuestos a estos desenlaces.
La vacuna, que está incluida en el Calendario Nacional de Vacunación y es gratuita para estas poblaciones, actúa como barrera para reducir el riesgo de complicaciones, hospitalizaciones e incluso fallecimientos.
“La hospitalización por influenza es una de las consecuencias más graves de la infección por este virus”, señalaron los autores del trabajo. El estudio fue publicado en la Revista Americana de Medicina Respiratoria (RAMR) y sus resultados se presentaron en Flu Forum 2025, una instancia de actualización científica sobre el virus organizada por CSL Seqirus.

El doctor Martín Sívori, jefe de la Unidad de Neumotisiología del Hospital Ramos Mejía y director del Centro Universitario de Neumonología “Dr. José María Ramos Mejía” de la UBA, lideró la investigación. Su equipo analizó los costos directos que implican estas hospitalizaciones. La conclusión fue contundente: una dosis de vacuna antigripal representa menos del 1 % de los costos que se generan cuando un paciente requiere internación por neumonía.
“Si todos los mayores de 65 años o los menores con factores de riesgo se vacunaran, significaría un ahorro enorme para el sistema de salud, pero también se ahorraría el deterioro de la calidad de vida que implican las complicaciones e internaciones, muchas de ellas evitables”, explicó Sívori.
En promedio, los pacientes del estudio permanecieron un día en guardia y siete días en sala general. Uno de los casos analizados terminó en fallecimiento. El costo directo de la internación fue de 2663 dólares por persona. A esto se suman otros gastos, como medicación, insumos, personal y seguimiento. La estimación no incluye el lucro cesante ni los llamados costos indirectos, que, según los especialistas, pueden multiplicar entre tres y cinco veces el valor de la hospitalización.
“Vacunar es una estrategia económica, eficaz y salva vidas. Aumentar la cobertura en otoño evitaría miles de hospitalizaciones y muertes prevenibles”, enfatizó el neumonólogo.
El doctor José Montes, médico infectólogo y director médico de CSL Seqirus para Argentina y Latinoamérica, también subrayó la relación costo-beneficio de la vacuna. “Este trabajo demuestra de manera clara el beneficio de la vacunación antigripal más allá de la salud de las personas, en la salud del sistema sanitario: una dosis de vacuna representa menos del 1 % de los costos directos asociados a una internación”, reiteró.

Durante la recolección de datos, los investigadores detectaron que los pacientes hospitalizados eran, en su mayoría, adultos mayores —alrededor de 70 años— y hombres. Presentaban una carga alta de comorbilidades: tabaquismo actual o previo, enfermedades cardiovasculares, diabetes, enfermedad pulmonar obstructiva crónica (EPOC), asma y consumo excesivo de alcohol, entre otras.
“Tenían criterio de vacunación el 100 % de los pacientes, pero solo el 28,5 % la había realizado el año previo”, insistió Sívori. La falta de adherencia a una indicación sanitaria gratuita y de fácil acceso genera consecuencias clínicas y económicas que podrían evitarse.
Los autores del trabajo expresaron su preocupación por la baja cobertura: “A pesar del daño respiratorio y sistémico a corto y mediano plazo de la infección por influenza, y relatando solo los costos directos, sabiendo que los indirectos son terriblemente superiores, resulta paradójico que, en nuestro país, donde la vacunación antigripal está dentro del Programa Nacional de Vacunación de Argentina para las poblaciones de riesgo de forma gratuita, la cobertura vacunal sea tan pobre”.

Por esa razón, insistieron en que “es imperativo extremar las medidas para asegurar una mayor cobertura vacunal en la población de riesgo”. Para los expertos, garantizar que la inmunización llegue en tiempo y forma a quienes la necesitan es una medida clave. “Es de suma importancia sanitaria para disminuir las internaciones y la mortalidad, las cuales son prevenibles junto con sus costos asociados”, concluyeron.
La vacuna antigripal está incluida en el Calendario Nacional de Vacunación, por lo que su aplicación es gratuita en grupos priorizados.
Esto incluye a mayores de 65 años, personas gestantes, puérperas hasta 10 días después del parto, niños de 6 a 24 meses, personal de salud y personas con factores de riesgo como obesidad, diabetes, enfermedades respiratorias o cardíacas, inmunodeficiencias, patologías oncohematológicas, pacientes trasplantados o en diálisis, entre otros.

Se estima que, durante las temporadas en que los virus de la vacuna coinciden con los que circulan, la inmunización reduce entre un 40 y un 60 % el riesgo de tener que consultar al médico por gripe. Además, disminuye las posibilidades de complicaciones respiratorias graves como la neumonía, principal causa de hospitalización por influenza en adultos mayores.
En lo que va de 2025, según el Boletín Epidemiológico Nacional, ya se registraron 19 fallecimientos por influenza en personas internadas. Las cifras muestran un aumento sostenido en la detección del virus desde mediados de marzo, lo que refuerza la importancia de vacunar de manera anticipada, especialmente en otoño, cuando comienza a aumentar la circulación viral.
“Si extrapoláramos este costo al total de pacientes que se internan año a año por neumonía en el país, implicaría una cantidad de miles o millones de dólares, una cifra terriblemente superior a lo que significa una campaña de vacunación, cuya cobertura debería alcanzar a más del 90 % de la población”, planteó Sívori.

A futuro, los investigadores consideran clave continuar generando evidencia sobre el impacto de la vacunación, no solo en la salud individual, sino también en el funcionamiento del sistema. Prevenir hospitalizaciones, muertes evitables y complicaciones severas no depende únicamente de la infraestructura, sino también de decisiones que se toman a tiempo.
En esa línea, el equipo del Hospital Ramos Mejía remarcó la necesidad de reforzar las estrategias de comunicación, identificar barreras de acceso y aumentar la conciencia colectiva sobre el valor de la vacunación. La gripe no es una enfermedad menor, y la neumonía asociada a este virus sigue representando un desafío en salud pública.
Frente a un escenario donde se dispone de vacunas eficaces, seguras y gratuitas, mejorar la cobertura no es solo un deber sanitario, sino también una política de salud inteligente. La prevención, en este caso, no solo salva vidas: también cuida los recursos de todos.
En sesión de la comisión de Gobernación, Administración Pública y Asuntos Electorales de la LXI Legislatura local, se presentó un plan de trabajo con la calendarización tentativa para elaborar el dictamen de Reforma electoral, que tendrá las reglas para el proceso 2026-2027. El presidente de la Comisión, Sinuhé Piedragil Ortiz, señaló q
Plaza de Ármas
El especial de The Punisher: One Last Kill llega por fin a Marvel para darle todo el protagonismo al antihéroe de Jon Bernthal. El actor regresa una vez más a su personaje tras los eventos de la primera temporada de Daredevil: Born Again. Además, sabemos que aparecerá en Spider-Man: Brand New Day, por lo que […]Seguir leyendo: ¿A qué ho
Hipertextual
Desde DC Climate Week, Nelly Ramírez analiza por qué la transición energética choca hoy con límites físicos reales y qué significa eso para México.
El Financiero
En un mundo que se mueve cada vez más rápido, encontrar un espacio de calma se ha vuelto una necesidad fundamental. El yoga no es solo una disciplina física, es una herramienta integral que transforma la relación entre el cuerpo y la mente.
Lado.mx
El problema del progreso sin control En el mundo del fitness moderno, uno de los mayores errores no es la falta de esfuerzo, sino la falta de control sobre el proceso. Muchas personas entrenan intensamente, siguen dietas estrictas y buscan resultados rápidos sin entender cómo responde realmente el cuerpo.
Lado.mx
La compañía presenta una nueva solución diseñada para mejorar la ergonomía en entornos de trabajo flexibles, integrando funcionalidad, diseño compacto y conectividad en un solo dispositivo. Colebrook Bosson Saunders ha anunciado el lanzamiento de LANA, un soporte ergonómico para laptops concebido para responder a las nuevas dinámicas del tr
Lado.mx
Un artículo detalla las causas y consecuencias de una deficiencia que afecta a millones de personas. Explica qué alimentos aportan más magnesio por porción para corregirla sin recurrir a suplementos
Infobae
Guilt Trip inicia su mayor gira por el Reino Unido y EuropaLa banda Guilt Trip lanzará su gira más ambiciosa en el Reino Unido y Europa este otoño, con importantes invitados.Este artículo es un contenido original de Monterrey Rock
Monterrey Rock
El peso, el ritmo y el tipo de superficie influyen en el gasto energético, pero los especialistas destacan que la caminata diaria aporta beneficios duraderos más allá de las calorías perdidas
Infobae
Alejandro Ávila Veracruz, Ver.- El presidente del Colegio Nacional de Abogados Penalistas, Jorge Reyes Leo...El cargo Denuncian página de Facebook en Medellín de Bravo por presunta violencia de género apareció primero en Sigüenza Comunica.
Sigüenza Comunica
Xalapa, Ver., 11 de mayo de 2026.- La gobernadora de Veracruz, Rocío Nahle García, abordó...El cargo Rocío Nahle anuncia apoyo a municipios, revisión del calendario escolar y nuevos espacios para gimnasia apareció primero en Sigüenza Comunica.
Sigüenza Comunica
Lo que antes era gratis, ahora la UV pagará por licencias Microsoft• En mayo proceso...El cargo Tras perder licencias Microsoft, ahora UV busca lanza licitación para adquirirlas apareció primero en Sigüenza Comunica.
Sigüenza Comunica
Servicio Meteorológico Nacional
Reconozco que sin demasiadas expectativas, dispuesto a aceptar que simplemente era algo para pasar la tarde pero, ey, que tiene duelos con katanas y eso siempre viene bien para echar la tarde del sábado. Y pronto me encuentro con que el primer episodio termina y que estoy deseando que
3d Juegos
Las plataformas de streaming necesitan generar más contenido y hay que buscar minas de creatividad en todos los espectros posibles. Apple TV por fin puso sus ojos en las novelas de Brandon Sanderson y ahora le ha llegado el turno a otro de los grandes fenómenos de la literatura como
Vida Extra
Bohemia Interactive hace años que buscó abrir sus alas e ir más allá de la saga ARMA, que tantos buenos resultados le había dado. Por eso, en 2023 anunció Bohemia Incubator, un programa de apoyo a juegos pequeños o ideas que el equipo de desarrollo quería ver convertidas en jue
3d Juegos
El número uno del mundo, Jannik Sinner, avanzó a semifinales del Masters 1000 de Madrid este miércoles tras imponerse al joven español Rafael Jódar por 6-2 y 7-6 (7-0). Sinner se medirá por una plaza en la final al ganador del encuentro entre el francés Arthur Fils y el checo Jiri Lehecka en el último […]La entrada Sinner gana a Jóda
Versus.com.py
Top-seeded Jannik Sinner saved all seven break points he faced and stretched his winning streak to 21 matches by taking down Rafael Jodar 6-2, 7-6 (0)
Deadspin
No. 2 seed Alexander Zverev defeated fast-rising Belgian Alexander Blockx for the second time in as many weeks while Spanish phenom Rafael Jodar battl
Deadspin
Paris Jackson reaccionaa en redes sociales ante la comparación entre artistas y recuerda la visión musical de su padre, Michael Jackson
Soycarmin
En Michael, el biopic que vuelve a poner bajo los focos la vida de Michael Jackson, no todo lo que falta es casualidad. Entre reconstrucciones, silencios familiares y decisiones creativas, hay ausencias que pesan tanto como las escenas que sí aparecen en pantalla. La película, dirigida por Antoine Fuqua y protagonizada por Jaafar Jackson se [R
Marie Claire
A solo un día del estreno mundial en cines de Michael, la biopic sobre Michael Jackson , su hija Paris Jackson ha dejado clara su postura definitiva: no forma parte del proyecto y solo desea que se cuente la historia de su padre con “amor y luz”. La cantante y modelo, de 28 años, reveló que leyó un primer borrador [
Entrelineas
Últimas noticias
Liga MX Femenil | América buscará terminar su sequía de títulos ante Rayadas en la Final Clausura 2026; conoce fechas y horarios
Mujer muere atropellada en carretera a Etla; permanece como no identificada
Denuncian corte de electricidad en Alcozacán, donde se refugiaban desplazados
Lunes con 44 ejecutados
Chocomanía: Krispy Kreme x Carlos V y Crunch
Encuentran persona sin v.da en estado de descomp.sición
Trump anuncia que EU hablará con Cuba, “un país en quiebra”
...LOS ANUNCIOS, AVISOS Y DEMÁS! - MARTES, 12 DE MAYO 2026
LA PORTADA - MARTES 12 DE MAYO 2026
Incendian vivienda en El Granjero tras irrumpir por la fuerza
Queman en San Ángel vehículo con reporte de robo
Otra corte exige a ICE permitir fianza a inmigrantes
Gobierno de Sheinbaum ha disminuido en 40% los homicidios diarios: SSPC
Temores e ilusiones
Filadelfia, la apuesta asequible para disfrutar el Mundial 2026